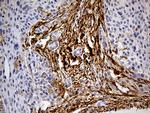
MRC2 Antibody in Immunohistochemistry (Paraffin) (IHC (P))

Search
OriGene
MRC2 Monoclonal Antibody (OTI9G4), TrueMAB™
{{$productOrderCtrl.translations['antibody.pdp.commerceCard.promotion.promotions']}}
{{$productOrderCtrl.translations['antibody.pdp.commerceCard.promotion.viewpromo']}}
{{$productOrderCtrl.translations['antibody.pdp.commerceCard.promotion.promocode']}}: {{promo.promoCode}} {{promo.promoTitle}} {{promo.promoDescription}}. {{$productOrderCtrl.translations['antibody.pdp.commerceCard.promotion.learnmore']}}
产品信息
TA811858
种属反应
宿主/亚型
分类
类型
克隆号
抗原
偶联物
形式
浓度
规格
纯化类型
保存液
内含物
保存条件
运输条件
靶标信息
May play a role as endocytotic lectin receptor displaying calcium-dependent lectin activity. Internalizes glycosylated ligands from the extracellular space for release in an endosomal compartment via clathrin-mediated endocytosis. May be involved in plasminogen activation system controlling the extracellular level of PLAUR/PLAU, and thus may regulate protease activity at the cell surface. May contribute to cellular uptake, remodeling and degradation of extracellular collagen matrices. May play a role during cancer progression as well as in other chronic tissue destructive diseases acting on collagen turnover. May participate in remodeling of extracellular matrix cooperating with the matrix metalloproteinases (MMPs).
仅用于科研。不用于诊断过程。未经明确授权不得转售。
篇参考文献 (0)
生物信息学
蛋白别名: C-type lectin domain family 13 member E; C-type mannose receptor 2; CD280; endocytic receptor (macrophage mannose receptor family); Endocytic receptor 180; Macrophage mannose receptor 2; unnamed protein product; UPAR-associated protein; Urokinase-type plasminogen activator receptor-associated protein
基因别名: CD280; CLEC13E; ENDO180; KIAA0709; MRC2; UPARAP
UniProt ID: (Human) Q9UBG0
Entrez Gene ID: (Human) 9902